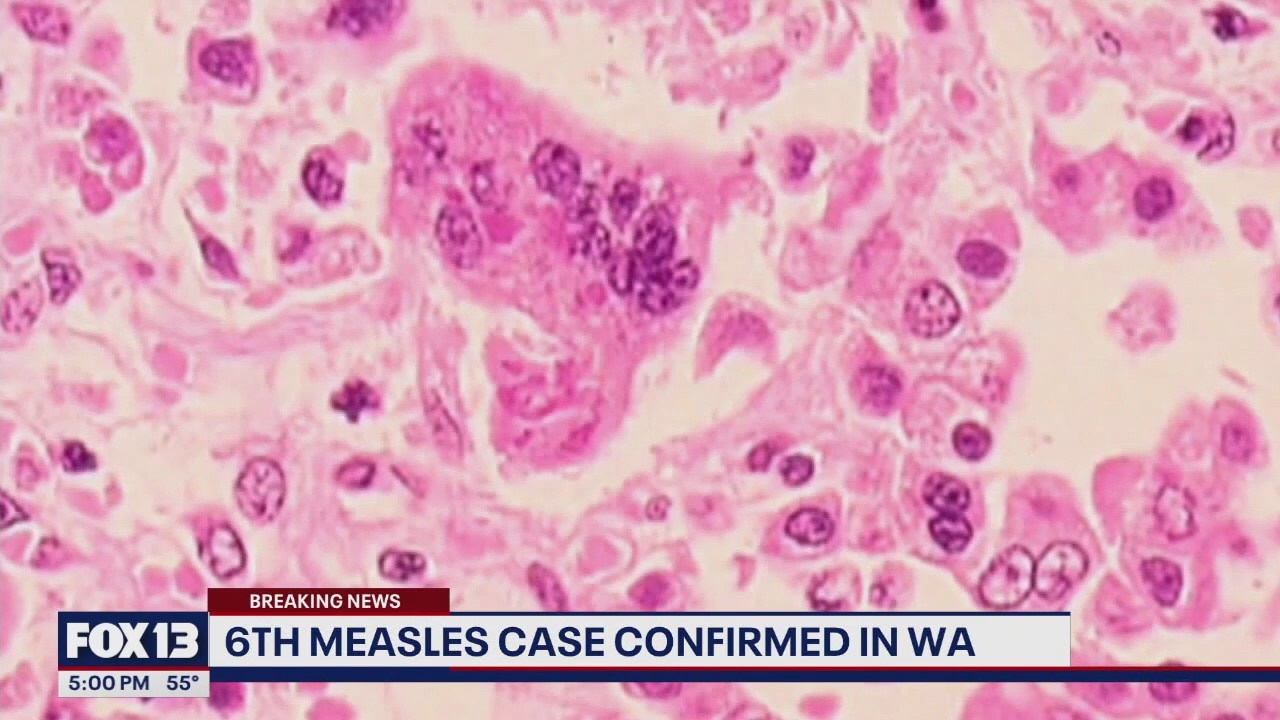

6th WA measles case confirmed in western WA
A sixth measles case in Washington was confirmed in a King County adult, who visited Seattle-Tacoma Airport and Overlake Medical Center while infectious.
Top Videos
6th WA measles case confirmed in western WA

New ‘Raising Cane's’ opens in Lynnwood, WA

Qatar fans ready for World Cup match

Bosnia and Herzegovina fans march to Seattle Stadium

Options for getting around during World Cup match

Bosnia and Herzegovina fans ready for World Cup match

Pet Tricks for Wednesday, June 24

Vigil held for victim of Longview plant implosion

1 man killed in Renton rollover crash

Columbia fans celebrate World Cup match win in Seattle

US Senate votes against war in Iran

Seattle News Tonight for Tuesday, 6/23

Washington News Wrap for Tuesday, 6/23

World Cup crowds take over downtown Seattle

Pub owner scrambles to serve World Cup crowds

Sinking ferry disrupts Lake Union weddings

World Cup match sparks Seattle security alerts

Bosnia and Qatar face off at Seattle Stadium

Ballard restaurant closes amid worker strike

Swimmer rescued at Mount Baker Beach

Good Day Seattle for Tuesday, 6/23

Social media safety for teens

Several WA beaches closed due to high bacteria

Flight Club Seattle offers World Cup activations

Seattle's Revel serves dishes of the World Cup
